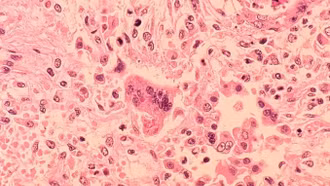
Trẻ tử vong do biến chứng sởi hiếm gặp tại Los Angeles (Mỹ)

Trẻ tử vong do biến chứng sởi hiếm gặp tại Los Angeles (Mỹ)
Một trẻ trong độ tuổi đi học tại Quận Los Angeles (Mỹ) đã tử vong do biến chứng hiếm gặp của bệnh sởi sau khi mắc bệnh từ khi còn nhỏ.
Một trẻ trong độ tuổi đi học tại Quận Los Angeles (Mỹ) đã tử vong do biến chứng hiếm gặp của bệnh sởi sau khi mắc bệnh từ khi còn nhỏ.

Mặc dù các phương tiện truyền thông đại chúng đã dành nhiều thời lượng tuyên truyền về phòng tránh bệnh sởi, về chiến dịch tiêm vaccine sởi, nhưng vẫn có nhiều phụ huynh “quên” tiêm phòng cho con. Điều đó khó tránh khỏi nhiều bệnh nhi nhập viện với biến chứng nguy hiểm.

Tính từ đầu năm 2025 đến nay, cả nước ghi nhận rải rác 76.312 trường hợp nghi sởi tại 63 tỉnh, thành phố, trong đó có 8.614 trường hợp dương tính, trong đó có 10 trường hợp tử vong.

Thời gian qua, thực hiện chỉ đạo của Thủ tướng Chính phủ về việc đẩy nhanh tiêm chủng vaccine phòng, chống bệnh sởi, Bộ Y tế đã triển khai đồng bộ các giải pháp đẩy nhanh tiến độ tiêm chủng.

Trong bối cảnh số ca mắc sởi tăng cao, các hình thái thời tiết lại đang dễ dàng dẫn tới việc lây lan bệnh sởi, dẫn tới nguy cơ dịch bùng phát là rất cao.... Hà Nội đã quyết mở rộng độ tuổi tiêm vaccine, giúp xây nhanh hàng rào miễn dịch, nhanh chóng ngăn chặn dịch.

Bộ Y tế đề nghị Sở Y tế các tỉnh, thành phố trên cả nước khẩn trương xây dựng kế hoạch và tổ chức ngay chiến dịch tiêm vaccine phòng, chống dịch sởi năm 2025 trên địa bàn ngay sau khi vaccine được cung ứng, không để muộn quá một tháng kể từ khi nhận được vaccine theo kế hoạch và báo cáo kết quả theo quy định.